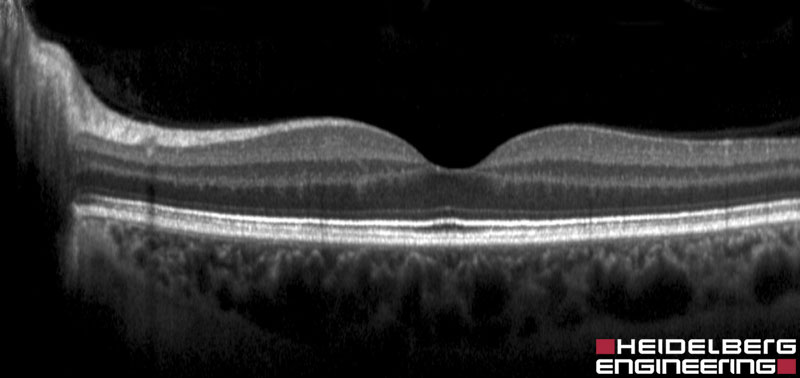
OCT-Aufnahme einer gesunden Netzhaut

General
Die perfekte Aufnahme | SPECTRALIS BluePeak
PDF-Tutorial | 4 Seiten
Erfahren Sie in diesem PDF-Tutorial, wie der Ablauf einer allgemeinen OCT-Untersuchung sowie einer BluePeak-Aufnahme ist und welche individuellen Optimierungsmöglichkeiten es durch verschiedene Aufnahmeeinstellungen gibt. Ebenso werden verschiedene Scanmuster sowie deren Anwendung erläutert und wie Sie durch die gezielte Veränderung von Scaneinstellungen auch myope und astigmatische Augen mit hoher Qualität aufnehmen können.
Laden Sie das PDF-Tutorial in den folgenden Sprachen herunter: